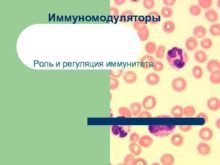

Острая надпочечниковая недостаточность Подготовила студентка 5 курса 59
Кафедра физики математики и информатики Тема Биомеханические особенности
Эстетические свойства ландшафтов и их оценка Эстетическая ценность
Системы вентиляции и кондиционирования воздуха Санкт-Петербургский политехнический
Состояние современной системы дошкольного образования Федеральный закон
КОНЦЕПЦИЯ РАЗВИТИЯ РЕЛЕЙНОЙ ЗАЩИТЫ И АВТОМАТИКИ ЭЛЕКТРОСЕТЕВОГО КОМПЛЕКСА
Министерство транспорта Российской Федерации Федеральное Агентство морского и